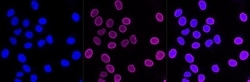
Invitrogen ARF6 Recombinant Rabbit Monoclonal Antibody (23GB3160), Invitrogen

missing translation for 'onlineSavingsMsg'
Learn More
Learn More
Invitrogen™ ARF6 Recombinant Rabbit Monoclonal Antibody (23GB3160), Invitrogen™
Rabbit Recombinant Monoclonal Antibody
Brand: Invitrogen™ MA553391
This item is not returnable.
View return policy
Description
ARF6 (ADP-ribosylation factor 6) is a broadly expressed, differentially regulated GTPase that is present in cytoplasm and on both cell-surface and intracellular membranes and whose functions may include tissue-specific effects on vesicular trafficking during cellular differentiation.
Specifications
| ARF6 | |
| Recombinant Monoclonal | |
| 0.8 mg/mL | |
| PBS with 50% glycerol and 0.02% sodium azide; pH 7.4 | |
| P62330, P62331, P62332 | |
| ARF6 | |
| A synthetic peptide of human ARF6 (120-175AA). | |
| 20 μL | |
| Primary | |
| Human, Mouse, Rat | |
| Antibody | |
| IgG |
| Flow Cytometry, Western Blot, Immunocytochemistry | |
| 23GB3160 | |
| Unconjugated | |
| ARF6 | |
| ADP ribosylation factor 6; ADP-ribosylation factor 6; AI788669; ARF6; AW496366; DKFZp564M0264 | |
| Rabbit | |
| Affinity chromatography | |
| RUO | |
| 11845, 382, 79121 | |
| -20°C | |
| Liquid |
Product Content Correction
Your input is important to us. Please complete this form to provide feedback related to the content on this product.
Product Title
Spot an opportunity for improvement?Share a Content Correction